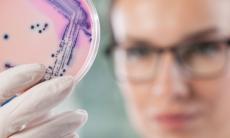
Lucruri neasteptate care au mai multi microbi decat ati crede

Articole medicale Medicina Generala
Medicina Generala
-
Factorii care provoaca meteosensibilitatea
Maraton Forte face parte din categoria suplimentelor nutritive recomandate barbatilor care sufera de ejaculare precoce sau disfunctie erectila, dar si celor care isi doresc performante sexuale...
-
Baile sau dusurile fierbinti pot fi periculoase?
In sezonul rece, baile fierbinti sunt ocazii bune de relaxare, insa nu sunt recomandate pentru toata lumea. De exemplu, baile sau dusurile fierbinti sunt contraindicate femeilor insarcinate,...
-
Cum combati retentia de apa
Retentia de apa se manifesta atunci cand organsimul retine o cantitate mai mare de apa decat in mod obisnuit (cantitatea normala de lichid retinut este de 1 litru pe zi). Se manifesta cel mai...
-
Aveti insomnii? Iata ce trebuie sa faceti pentru un somn linistit
Multe persoane se confrunta cu insomnie si, oricat ar incerca, nu reusesc sa gaseasca o solutie salvatoare. De vina poate fi stresul, uneori chiar oboseala sau anumite afectiuni. Cu toate...
-
Secrete pentru o viata lunga si sanatoasa
Asa cum unele obiceiuri va pot imbolnavi, altele va pot mentine sanatatea la cote maxime si va pot prelungi viata.
-
Cat de sanatoase sunt cocktailurile?
Exista studii care sustin ca un consum moderat de alcool ofera beneficii asupra organismului, inclusiv ca ar contribui la cresterea sperantei de viata.
-
Riscurile utilizarii hartiei igienice colorate si parfumate
Folosirea hartiei de toaleta colorata si parfumata implica o serie de riscuri, ea putand cauza anumite infectii ale uretrei, crescand astfel riscul dezvoltarii cancerului de colon, iar anumite...
-
Bauturile energizante - efectul real al acestora
Multi oameni au obiceiul sa consume bauturi energizante fie pentru ca se simt obositi, fie din placere, insa putini stiu sau sunt constienti de efectele acestora asupra sanatatii si mai ales ce...
-
Lucruri neasteptate care au mai multi microbi decat ati crede
Multe obiecte pe care avem obiceiul de a le utiliza zilnic, fie din necesitate, fie din placere, contin foarte multi microbi si bacterii care ne pot imbolnavi.
-
Motive pentru care este bine sa mancati oua
Ouale sunt foarte bune pentru sanatate, deoarece contin aminoacizi, vitamine, minerale si proteine. Insa, sunt si bogate in colesterol si de aceea nu este indicat sa consumati prea multe. Cu...
-
Ce bauturi si alimente interactioneaza cu medicamentele
Anumite medicamente nu pot fi luate daca urmati in acelasi timp inca o schema terapeutica comupsa din alt tip de pastile sau daca mancati anumite alimente, intrucat toate acestea pot avea efecte...
-
Obiceiuri care v-ar putea afecta sanatatea
Foarte multe obiceiuri pe care le-ati deprins in copilarie sau pe parcurs, desi par inofensive, pot dauna sanatatii. De aceea este bine sa fiti constienti de riscurile lor si sa le corectati.
-
Cat de periculoase sunt produsele pastrate in ambalajele din aluminiu?
Aluminiul se gaseste pretutindeni in mediul inconjurator, motiv pentru care este greu de evitat. Practic, aluminiul este utilizat in industrie, intrucat este un material usor, dar si un bun...
-
Poti sa intrerupi antibioticele daca te simti mai bine?
In general, tendinta unei persoane atunci cand prezinta anumite dureri, viroze sau infectii este aceea de a se trata singura. De fapt, problema se regaseste la nivel global, daca tinem cont de...
-
Chimicalele din haine care iti pun sanatatea in pericol
Este stiut faptul ca aproape intodeauna cand mergem la cumparaturi ne facem griji pentru calitatea produsului alimentar pe care-l achizitionam, insa produsele alimentare nu ar trebui sa constituie...
Specialitati medicale
- Alergologie-Imunologie
- Analize medicale
- Cardiologie
- Chirurgie generala
- Chirurgie plastica
- Dermatologie-Estetica
- Diabet, nutritie, boli metabolice
- Diete-Nutritie
- Endocrinologie
- Flebologie
- Gastroenterologie
- Ginecologie
- Hematologie
- Homeopatie
- Imagistica Medicala
- Infectioase
- Medicina alternativa
- Medicina Generala
- Medicina interna
- Nefrologie
- Neurologie
- Oftalmologie
- Oncologie
- ORL
- Ortopedie
- Pediatrie
- Pneumofiziologie
- Proctologie
- Psihologie-Psihiatrie
- Recuperare medicala
- Reumatologie
- Sanatate sport
- Sarcina
- Sexologie
- Stomatologie
- Urologie
-
Interpretare simptome
semnificatia simptomelor si afectiunile probabile
Afla acum

Urmareste Sfatul Medicului
Aboneaza-te la Newsletter